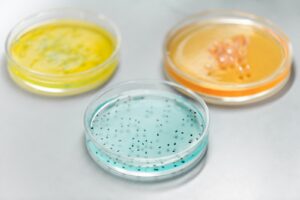

Water Damage Restoration
When Water Damage Happens,
We're Here to Help
Genuine Care & Empathy
Rooted In Family, Driven By Service
We understand the emotional toll that water damage can have on a family, and we are here to provide support and reassurance during this challenging time. Our compassionate team will guide you through the process, answering your questions, addressing your concerns, and working diligently to restore your home to its pre-damage condition.
Rebuild Your Home, Rebuild Your Life
We believe that water damage restoration is not just about repairing physical structures; it’s about restoring hope, providing support, and helping families rebuild their lives. Our work goes beyond technical expertise; it is a testament to our commitment to empathy, compassion, and unwavering dedication.
Services we offer
Damage Restoration Services
Meet the Family
With a personal touch and a commitment to excellence, we’re here to help our community recover from water damage. Trust us to restore your property with care and expertise

Owners
Latest Articles

Water Damage Cleanup vs Restoration: What Georgetown & Austin Property Owners Should Know
Many property owners assume cleanup and restoration are the same — but they are very different. Understanding the difference helps you choose the right service and avoid long-term damage. What Is Water

Emergency Restoration Services in Georgetown & Austin, TX: When Fast Response Matters Most
Disasters don’t follow business hours. Water damage, storms, and unexpected emergencies can strike at any time — and fast response is the most important factor in minimizing damage. RestoTek offers 24/7 emergency
Mold Remediation in Georgetown & Austin, TX: Signs, Risks, and When to Call a Professional
Mold is one of the most common — and most misunderstood — issues facing Central Texas property owners. High humidity, water damage, and poor ventilation create ideal conditions for mold growth in